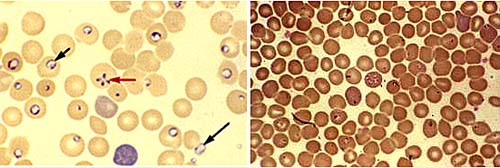

Trong thực hành xét nghiệm, đặc biệt là xét nghiệm chuyên ngành sốt rét và ký sinh tùng, khi chúng ta làm lam máu rồi nhuộm giêm sa hoặc Wright soi dưới kính hiển vi, không phải lúc nào cũng phát hiện ra có hay không các loài ký sinh trùng sốt rét mà còn gặp phải các loại đơn bào và ký sinh trùng khác, có thể trong số chúng thì chúng ta có thể đã gặp hoặc có lúc nào đó nghĩ đến song không có cơ sở để khẳng định tác nhân gây bệnh (Blood smear analysis in babesiosis, ehrlichiosis, relapsing fever, malaria, and Chagas disease).
Các mầm bệnh này có thể gặp ở Việt Nam hoặc chưa gặp tại việt Nam mà trên các y văn quốc tế đã công bố. Trong bài viết này, chúng tôi xin tổng hợp về các hình ảnh đơn bào và ký sinh trùng mà chúng ta rất dễ nhầm lẫn với ký sinh trùng sốt rét khi xét nghiệm lam máu như chia sẻ cùng quý đồng nghiệp, đặc biệt là các xét nghiệm viên hàng ngày đối mặt với các hình ảnh như thế.
Nhóm tác giả gồm Steve M. Blevins (khoa nội tổng hợp, đại học khoa học Oklahoma, WP 1160, 920 Stanton Young Boulevard, PO Box 26901, Oklahoma City), Ronald A. Greenfield (khoa bệnh truyền nhiễm, đại học khoa học Oklahoma Health Sciences), Michael S. Bronze (cùng khoa bệnh truyền nhiễm) cùng tiến hành nghiên cứu và có bài tổng hợp liên quan đến phân tích các hình ảnh của lam máu đặc biệt hữu ích cho việc chẩn đoán 5 bệnh nhiễm trùng: Babesiosis, Ehrlichiosis, Relapsing fever do nhiễm trùng Borrelia, Sốt rét và bệnh Trypanosomiasis (bệnh Chagas). Các việc làm này nên thực hiện trên những bệnh nhân có tình trạng sốt tái phát hoặc kéo dài hoặc trên những người có tiền sử đi du lịch đến các quốc gia đang phát triển có phơi nhiễm hoặc tiếp xúc với ve, đặc biệt nếu đi kèm theo thiếu máu tan máu, giảm tiểu cầu và gan lách lớn.
Tại Mỹ, sốt rét và bệnh do đơn bào Trypanosoma spp. gây ảnh hưởng đến những người đidu lịch từ các quốc gia đang phát triển. Chứng nhiễm ký sinh trùng Babesia do ve bét gây nên (Babesiosis), bệnh nhiễm trùng vi khuẩn do ve bét truyền, loại vi khuẩn này thuộc họ Anaplasmataceae, giốngEhrlichia và Anaplasma, đây là các vi khuẩn nội bào bắt buộc nhiễm vào và gây chết các tế bào bạch cầu. Bệnh Ehrlichiosis, Sốt rái hồi (relapsing fever) được truyền bởi ve bét và có thể gây ra tình trạng giảm tiểu cầu và tăng men gan. Sốt rét và bệnh do Babesiagây nên tình trạng thiếu máu tan máu và có thể liên quan đến gan to lách to. Sốt tái hồi cũng điển hình coh bệnh sốt rét và nhiễm trùng Borrelia.
Phân tích các lam máu thường quy sử dụng đánh giá các tình trạng về máu, lại thường không dùng nó để đánh giá hoặc chẩn đoán các bệnh nhiễm trùng. Bởi vì điều này do tình hiếm của các bệnh khi chỉ định xét nghiệm máu để phân tích một cách thấu đáo. Do đó, các thử nghiệm hoặc xét nghiệm như vậy thường bị bỏ qua và không quan tâm đến trong khi đó là tầm quan trọng về mặt chẩn đoán. Các thay đổi không đặc hiệu có thể bào gồmthay đổi về mặt hình thái học của các tế bào hồng cầu và bạch cầu (chẳng hạn do quá trình tích hạt gây độc hoặc chứng tăng đại hồng cầu). Đối với một số tác nhân gây bệnh,việc xác định vi sinh vật trong mẫu máu ngoại vi cho phép chẩnđoán nhanh.
Trong nội dung bài viết thảo luận về mảng dịch tễ học, đặc điểm lâm sàng, xét nghiệm cận lâm sàng và quản lý ca bệnh của 5 bệnh truyền nhiễm trên, trong đó việc nhìn thấy trực tiếp các vi sinh vật trong máu đóng vai trò quan trọng trong chẩn đoán. Mong muốn là tóm tắt các dấu hiệu lâm sàng cùng với chỉ định xét nghiệm cận lâm sàng kịp thời, đặc biệt là phân tích hình ảnh và các thông số trong lam máu để tránh bỏ sót một số bệnh mà từ lâu chúng ta chưa quan tâm.
Bệnh do tác nhân Babesia (BABESIOSIS)
Babesiosis, một bệnh do đơn bào truyền thông qua ve bét, xảy ra chủ yếu tại Mỹ và châu Âu. Trong số hơn 100 loài Babesia, có hai loài trong đó gây bệnh cho người: B microti và B divergens. Cả hai loài này được truyền bởi các ve Ixodes, mặc dù các bệnh nhân thường không bị đốt lại. Bệnh có hiếm khi gây ra bởi khâu truyền máu. Hầu hết số ca xảy ra từ tháng 5 đến tháng 9, khi đó là quá trình phơi nhiễm giữa người với các con ve bét cao nhất. Thời gian ủ bệnh thay đổi trong bênh này từ 1-4 tuần.
|
Babesia microti thể nhẫn trong hồng cầu (trong mũi tên ngắn), thể nhẫn ngoại hồng cầu(mũi tên dài) và một thể maltese chéo “Maltese cross” (mũi tên đỏ) (qua tiêu bản nhuộm Giemsa độ phóng đại ×100). |
Bệnh thường gặp ở phía Đông bắc và không biểu hiện triệu chứng
Nhiễm trùng B. microti xảy ra nổi trội tại Mỹ. Các loài gặm nhấm, đặc biệt là các chuột chân trắng (white-footed mouse) đóng vai trò như ổ chứa chính của bệnh. Tại các vùng lưu hành bệnh, tỷ lệ dương tính huyết thanh (seropositivity rates) khoảng 4% - 21%, gồm các vùng ven biển và đảo của Massachusetts, đặc biệt tại vùng Cape Cod, Nantucket và Martha’s Vineyard; các đảo gần thành phố New York, đặc biệt Long Island, Shelter Island, Fire Island; Block Island, ngoại vi của Rhode Island và một số vùng trong Connecticut. WA-1, một loài có hình thể xác định với B. microti, đang nổi lên tại California và Washington.
Nhiễm trùng loài B. microti thường không biểu hiện triệu chứng. Trên những người già và suy giảm miễn dịch, đặc biệt cá nhân đó đã bị cắt lách hoặc suy giảm miễn dịch tế bào, thường có xu hướng bị bệnh nhiều hơn. Các triệu chứng nếu có thường bao gồm sốt, suy nhược, nhức đầu, buồn nôn, ngứa. Các triệu chứng này có thể kéo dài vài tuần đến vài tháng:
-Khoảng ¼ số bệnh nhân bị bệnh babesiosis có đồng nhiễm với bệnh Lyme (do Borrelia burgdorferi) và thường khi đó bệnh trở nên nghiêm trọng hơn;
-Gan lớn và lách lớn, vàng da và nước tiểu đỏ sậm là các triêu chứng có thể nhìn thấy trên các bệnh nhân có triệu chứng;
-Tan huyết nghiêm trọng thường đi kèm bởi tình trạng giảm tiểu cầu, giảm bạch cầu và tăng lympho bào không điển hình và thường gặp trên những bệnh nhân nguy cơ cao;
-Các men gan hoặc transaminases gan có thể tăng;
-Phân tích nước tiểu có thể cho thấy protein niệu và hemoglobin niệu;
-Suy hô hấp cấp tính cũng đã được báo cáo trên một số ca nhiễm nặng.
Nhiễm trùng B. divergens: Nghiêm trọng nhưng bệnh hiếm gặp tại các quốc gia châu Âu
B. divergens tìm thấy chủ yếu ở các quốc gia châu Âu. Nhìn chung, ít hơn 50 trường hợp nhiễm đã được báo cáo tại Pháp, Tây Ban Nha, Đức, Anh, Ireland, Yugoslavia và liên bang Sô Viết cũ. Gia súc cũng là ổ chứa bệnh chính của nhiễm trùng.
Nhiễm trùng B. divergens gây ra rất hiếm nhưng bệnh tàn phá chủ yếu ở những người không còn có lách, thường dẫn đến một hậu quả hon mê và tử vong. Không có trường hợp nào nhiễm trùng dạng tiền lâm sàng báo cáo. Biểu hiện lâm sàng nếu có thường rầm rộ và thiếu máu tan máu hay xảy ra.
Bệnh Babesia nghi ngờ tại các vùng lưu hành khi có các ca “cúm” kéo dài
Bệnh Babesiosis nên được nghĩ đến khi một bệnh nhân sống hoặc có tiền sử đi du lịch đến các vùng lưu hành bệnh, nay lại có biểu hiện triệu chứng lâm sàng giống cúm kéo dài và có tan máu, có hoặc không có phì đại các tạng (organomegaly) hoặc vàng da. Chẩn đoán được xác lập nhờ vào phát hiện các ký sinh trùng trong hồng cầu thông qua xét nghiệm máu trên tiêu bản nhuộm Giemsa. Lam giọt mỏng có xu hướng chuộng hơn lam giọt dày do dễ nhìn thấy vi sinh vật. Mật độ ký sinh trùng trong máu có thể từ ít hơn < 1% đến hơn 80% số hồng cầu. Mật đọ ký sinh trùng cao xảy ra chủ yếu ở các bệnh nhân cắt lách hoặc đã bị chấn thương lách. Mật độ ký sinh trùng thấp, thì việc xét nghiệm lam máu càng tỷ mỉ càng tốt.
Đơn bào có thể tuowng tự như thể nhẫn của ký sinh trùng sốt rét. Phân biệt các đặc điểm bao gồm các vi sinh vật ký sinh ngoại hồng cầu; sự vắng mặt các hạt pigment trong các hồng cầu nhiễm và một dấu chéo Maltese (“maltese cross”) là một hình ảnh rất hiếm sinh ra bởi nhóm bốn merozoite của Babesia. Một hồng cầu nhiễm có thể chứa đến 8 ký sinh trùng. Phản ứng huyết thanh hoặc chuỗi khuếch đại PCR sẽ có ích khi vi sinh vật không được nhìn thấy qua soi lam máu.
Điều trị các bệnh nhân nhiễm nặng
Hầu hết bệnh nhân nhiễm trùng B. microti biểu hiện lâm sàng nhẹ và có thể tư khỏi mà không cần điều trị. Điều trị được khuyến cáo cho những đối tượng có mật độ ký sinh trùng trong máu cao. Các thuốc phù hợp có hoạt tính chống lại B. microti gồm có: Clindamycin (Cleocin), azithromycin (Zithromax), ato-vaquone (Mepron), doxycycline (Vibramycin), quinine (Quinamm). Liệu pháp phối hợp hoặc là clindamycin và quinine hoặc azithromycin và atovaquone được khuyến cáo dùng điều trị. Nhiễm trùng B. divergens được điều trị thành công với liệu pháp phối hợp clindamycin, quinine và truyền máu trao đổi.
EHRLICHIOSIS
Ehrlichiosis, có nickname là sốt Rocky Mountain “spotless”, là một bệnh gây ra do ve bét theo mùa và tác nhân gây bệnh là một loại vi khuẩn ký sinh nội bào bắt buộc. Vi khuẩn thuộc họ Ehrlichia phát triển bên trong các khoang không bào bào tương của bạch cầu và gây nên các nhiễm trùng từ động vật sang người chủ yếu. Một số loài, đặc biệt Ehrlichia chaffeensis và Anaplasma phagocytophilum, là các tác nhân được nhận ra là các tác nhân gây bệnh ở người. E chaffeensis nhiễm vào trong các tế bào đơn nhân, gây nên một tình trạng được biết như bệnh Ehrlichiosis đơn nhân ở người (HME). Một phagocytophilum nhiễm vào các bạch cầu đa nhân, sinh ra một tình trạng gọi là bệnh “human granulocytic anaplasmosis (HGA).
Những con hươu nai là các vật chủ chứa chính của mầm bệnh E. chaffeensis; các chuột chân trắng và các loại gặm nhấm khác và hươu nai là các vật chủ chứa chính của A. phagocytophilum. HME lây truyền thông qua các con ve Dermacentor và Ixodes và HGA lây qua con ve Ixodes. Nhiễm trùng ở người thường xảy ra vào mùa xuân và hè, khi đó là ve phơi nhiễm với người nhiều nhất. Đồng nhiễm của các ve bét với các vi sinh vật gây nên bệnh Lyme hoặc bệnh babesiosis có thể dẫn đến lan truyền cùng lúc nhiều bệnh khác nhau.
Hơn 1.000 ca bệnh HME được báo cáo mỗi năm tại đông nam, trung nam và giữa Atlantic của Mỹ. Tỷ lệ mắc HME tại Mỹ dường như đứng sau Rocky Mountain spotted fever. Một số ca đã được mô tả tại New England và vùng Pacific Northwest. Hơn 600 ca báo cáo về HGA đến từ bang Wisconsin, Minnesota, Connecticut, New York, Massachusetts, California, Florida và Tây Âu. Sự phân bố bệnh HGA theo sau là bệnh Lyme vì 2 bệnh này chia sẻ nhau cùng một loại trung gian truyền bệnh.
Khởi đấu với sốt cấp và đau cơ cấp tính
HME và HGA có thời gian ủ bệnh khoảng 1-2 tuần. Triệu chứng tương tự nhau và thường là diễn tiến cắp tính, thay đổi từ nhẹ đến nặng. Hầu hết các bệnh nhân có sốt, rét run, suy nhược, nhức đầu và đau cơ. Nhiều ca bệnh có buồn nôn, nôn mửa, ho và đau khớp. Các triệu chứng tương tự như bệnh sốt Rocky Mountain spotted fever (gây ra bởi Rickettsia rickettsii), ngoại trừ ban đỏ là không thường gặp trên các ca bệnh HME (gặp khoảng 1/3 số bệnh nhân) và hiếm gặp trên các ca HGA. Các khám nghiệm về thần kinh, như thay đổi cảm giác và cứng cổ, có thể đi kèm với tình trạng tăng bạch cầu lympho và nồng độ protein tăng trong dịch não tủy. Biểu hiện của các trường hợp tiền lâm sàng và bán cấp (sốt kéo dài đến 2 tháng) là không hay gặp. Một số trường hợp mạn tính đã được báo cáo.
Tỷ lệ tử vong ước tính là 1-10% và tỷ lệ nhập viện cao khoảng chứng 60%. Hầu hết các trường hợp tử vong xảy ra trên người già, thường theo sau các biến chứng như suy tim sung huyết, chèn ép tim, suy thận, co giật và hôn mê. Các bệnh nhân suy giảm miễn dịch có tiên lượng kém. Thời gian hồi phục có thể kéo dài.
Các bất thường trong xét nghiệm cận lâm sàng gồm có giảm bạch cầu, giảm tiểu cầu và tăng men gan. Giảm bạch cầu đi kèm theo giảm bạch cầu lympho và bạch cầu đa nhân trung tính. Giảm bạch cầu lympho xảy ra sớm trong giai đoạn đầu của bệnh và thường theo sau một tình trạng giảm bạch cầu lympho không điển hình. Các triệu chứng kéo dài liên quan đến việc giảm số lượng bạch cầu đa nhân trung tính và tăng bạch cầu neutrophile dạng dải băng.
Bệnh Ehrlichiosis được nghi ngờ khi bệnh nhân có sốt, giảm bạch cầu hoặc giảm tiểu cầu sống trong vùng lưu hành
Bệnh Ehrlichiosis nên được nghĩ đến trên các bệnh nhân có sốt có giảm bạch cầu hoặc tiểu cầu trước đó có phơi nhiễm với các ve trong vùng lưu hành. Ngay cả các bệnh nhân có số tế bào và men gan bình thường cũng nên được đánh giá nếu tình huống lâm sàng và dịch tễ cho thấy hướng về bệnh.
Xét nghiệm lam máu ngoại vi nên được làm, kể cả xét nghiệm intracytoplasmic (phôi dâu) trong các tế bào đơn nhân (đối với bệnh HME) và trong các tế bào đa nhân (đối với bệnh HGA). Xét nghiệm lam máu có thể rất nhạy dương tính trên các bệnh nhân có HGA hơn là HME. Vì số bạch cầu nhiễm có thể thấp, nên xét nghiệm hơn 500 bạch cầu trên tiêu bản nhuộm Wright là cần thiết và là yêu cầu. Xét nghiệm QBC (Buffy coat) cho phép tập trung phân tích các tế bào bạch cầu, nâng cao chẩn đoán.
|
Hình ảnh phôi dâu của Anaplasma phagocytophilum trong bào tương của bạch cầu đa nhân trung tính (mũi tên) (Nhuộm Wright, độ phóng đại x 100) |
Các xét nghiệm chẩn đoán khác gồm có phản ứng khuếch đại chuỗi DNA (PCR) và các xét nghiệm huyết thanh đã cho kết quả chính xác, độ nhạy và độ đặc hiệu cao. Vì các vi sinh vật này khó nuôi cấy trong điều kiện in vitro, nên các mẫu máu nuôi cấy không có hữu ích trong chẩn đoán. Điều trị
Doxycycline 100 mg, 2 lần mỗi ngày trong thời gian 7-10 ngày là phác đồ chọn lựa cho cả HME và HGA. Không thấy vai trò xác định đối với nhóm Fluoroquinolones trong điều trị bệnh này. Phòng tránh ve, bét chích hút máu và loại bỏ ve bét thích hợp là chiến lược phòng bệnh hiệu quả nhất.
RELAPSING FEVER
Sốt tái phát (Relapsing fever) là một bệnh lý sốt cấp gây ra bởi các loài xoắn khuẩn thuộc giống Borrelia. Bệnh có hai thể: gây ra do ve bét - hay còn gọi là nhiễm trùng ở người do động vật và thể gây ra do rận – trong đó người được xem là ổ chứa duy nhất của nhiễm trùng.
Một số ca bệnh gây ra do ve bét tại Mỹ
Bệnh gây ra do ve bét gây bởi nhiều loài Borrelia. Trong số đó tìm thấy phát hiện tại Mỹ, xảy ra chủ yếu ở vùng núi phía tây và các vùng đồng bằng vùng cao của phía tây nam nước Mỹ. Mỗi năm tại Mỹ có khoảng 30 trường hợp sốt dạng như thế này được chẩn đoán xác định do ve gây nên. Sốt tái phát do ve bét lây truyền bởi các con ve bét có thân mềm (giống Ornithodoros), chúng hoạt động ít hơn 1 giờ (thường vào ban đêm) và có thể sống đến nhiều năm mà không cần ăn máu. Chúng sống gần gũi với người và động vật. việc phơi nhiễm hoặc tiếp xúc thường xảy ra trong các căn phòng nhỏ, dưới điều kiện đang xây dựng, trong các hang động, gần các đống củi, đống gỗ và trong các căn phòng mà các con vật thường sống trong đó. Các loài gặm nhấm là các ổ chứađầu tiên. Ngược lại, hầu hết các bệnh gây ra bởi ve, bét khác - babesiosis, ehrlichiosis, bệnh Lyme, bệnh sốt Rocky Mountain spotted fever, Colorado tick fever thì thường lây truyền bởi các loài ve thân cứng (hard-bodied ixodid ticks), chúng sống trong các khu rừng rậm, bụi cây và dính vào “passersby”, và ăn trong vài ngày nếu không bị phát hiện và loại bỏ.
Bệnh gây ra do rận lưu hành ở châu Phi
Sốt tái phát do rận gây ra bởi các loài đơn giản, B. recurrentis, lưu hành ở Ethiopia và Sudan. Bệnh có thể xảy ra rải rác hoặc gây thành dịch bệnh. Chiến tranh, nạn đói và di dân hàng loạt có thể dẫn đến dịch xảy ra với tỷ lệ tử vong từ 30-70% nếu không được điều trị. Bệnh lan rộng trên người do chấy, rận ở cơ thể người (Pediculus humanus).
RELAPSING HIGH FEVERS
Đặc điểm lâm sàng của bệnh sốt gây ra do ve, bét hoặc chấy rận là giống nhau, mặc dù sốt tái phát do chấy, rận thường có thời gian ủ bệnh kéo dài. Tình trạng vãn khuẩn huyết hoặc nhiễm trùng huyết sẽ xảy ra theo sau giai đoạn sốt cấp (thường trên 39°C), đi kèm theo nhức đầu, buồn nôn, đau cơ và đau khớp. Trung bình, diễn tiến lâm sàng giảm bớt đi trong vòng 3 ngày khi bị sốt tái phát do ve, bét, nhưng có thể kéo dài 5-6 ngày trong bệnh sốt tái phát do chấy, rận. Khám thực thể cho thấy cảm giác và ý thức thay đổi, xuất hiện chấm xuất huyết, gan lách to và ửng đỏ kết mạc. Sốt sẽ lên đến cực điểm đặc trưng bởi một cơn rùng mình và tăng biểu đồ sốt dựng đứng, mạch nhanh và huyết áp tăng. Điều này theo sau bởi cơn sốt liên tục, chảy mồ hôi và hạ huyết áp. Nguy cơ tử vong là cao nhất trong suốt giai đoạn này và ngay sau đó.
Với sự giải quyết tình trạng nhiễm trùng huyết, giai đoạn không còn sốt nữa, kéo dài 4-14 ngày. Tiếp đó, sốt lại tái phát, dù có nhẹ hơn, rồi sốt lại có liên quan đến nhiễm trùng huyết. Trung bình, người bị sốt tái phát do ve, bét có 3 cơn tái phát; trong khi sốt tái phát do chấy rận chỉ có một cơn. Tái phát xảy ra vì thay đổi và dao động về tính kháng nguyên, trong đó kháng nguyên bề mặt của xoắn khuẩn bị thay đổi để xâm nhập vào hệ thống miễn dịch của vật chủ.
Borrelia có thể xâm nhập vào các cơ quan và hệ thần kinh
Với mỗi giai đoạn nhiễm khuẩn huyết, các xoắn khuẩn có thể xâm nhập vào não, gan, mắt, tim và tai trong. Liên quan đến hệ thần kinh trung ương thường gặp với nhiễm ve bét hơn là nhiễm chấy rận. Liên quan đến hệ thần kinh trung ương có thể gồm có liệt mặt, viêm tủy, bệnh lý rễ, mất ngôn ngữ, liệt ½ người, rung rủ cánh hoặc hôn mê. Viêm cơ tim, thường cả hai thể của loại sốt tái phái, báo hiệu một tình trạng tiên lượng nặng. Xâm nhập vào mắt hoặc tai có thể dẫn đến suy giảm mắt và tai hoặc chóng mắt. Rối loạn xuất huyết, có đặc điểm chảy máu cam, chấm xuất huyết và mảng xuất huyết là bệnh lý sốt tái phát do chấy rận điển hình, có liên quan đến đông máu nội mạch rải rác mức độ thấp. Lách to thường gặp trong bệnh sốt do chấy rận hơn là do ve bét.
Các xét nghiệm hỗ trợ
Các xét nghiệm cận lâm sàng gồm có thiếu máu hồng cầu bình thường, tăng bạch cầu và giảm tiểu cầu. Tăng men gan có thể và các test đông máu kéo dài. Các bệnh nhân có bệnh lý liên quan đến tim có thể có kéo dài khoảng QTc. Phù phổi và tim lớn có thể nhìn thấy trên phim chụp X-quang.
Dịch não tủy trên những bệnh nhân có biểu hiện thần kinh có tình trạng tăng bạch cầu đơn nhân và tăng nhẹ nồng độ protein trong máu.
Nghi ngờ bệnh nếu nghĩ sốt tái hồi/ hồi quy trong vùng lưu hành
Chẩn đoán nên được nghi ngờ trong các vùng lưu hành bệnh trên các bênh nhân có sốt tái phát trước đó có phơi nhiễm với ve hoặc chấy, rận. Chẩn đoán xác định khẳng định nhờ vào xét nghiệm lam máu trong giai đoạn sốt. Các xoắn khuẩn có thể nhìn thấy trên các lam giọt mỏng hoặc giọt đặc qua nhuộm Wright và Giemsa. Các vi sinh vật không thể phát hiện giữa các giai đoạn có sốt. Các thử nghiệm huyết thanh học có thể không đáng tin cậy và có thể dương tính giả với bệnh giang mai vì bệnh Lyme và giang mai có thể đồng thời xảy ra.  |
Hình 3. Xoắn khuẩn thuộc giống Borrelia (nhuộm Wright, độ phóng đại × 100). |
Điều trị
Sốt tái phát có thể điều trị thành công bằng thuốc kháng sinh tetracycline, penicillin hoặc erythromycin. Liệu trình điều trị ưa dùng trên các phụ nữ không mang thai bị sốt do chấy rận là liều duy nhất 0.5g Tetracycline. Trong sốt tái phát do ve bét, liều 0.5g tetracycline 4 lần mỗi ngày trong 5-10 ngày là liều khuyến cáo. Viêm màng não hoặc viêm não thường được điều trị bằng penicillin hoặc ceftriaxone (Rocephin) đường tiêm. Tỷ lệ tử vongtrên ca bệnh được điều trị thường < 5%. Điều trị có thể gây ra hội chứng hay phản ứng Jarisch-Herxheimer (ớn lạnh và hạ huyết áp, kèm theo cơn sốt), các bệnh nhân phải được theo dõi chặt chẽ trong vòng 4 giờ sau khi cho các loại kháng sinh này. Tránh tiếp xúc với các ve bét và thực hành tốt vệ sinh cá nhân để ngăn ngừa nhiễm phải mầm bệnh.
SỐT RÉT
Sốt rét gây ra bởi một loại đơn bào thuộc giống Plasmodium. Bị đốt do muỗi, các thoi trùng đi vào trong dòng máu và di chuyển đến gan. Trong suốt quá trình giai đoạn gan không có triệu chứng, thoi trùng nhân lên trong tế bào gan để thành thể phân liệt trưởng thành. Trong vòng 1-2 tuần, các thể schizont vở ra, ly giảihàng ngàn thể merozoite vào trong dòng máu. Các merozoites vào trong các hồng cầu, ở đó chúng trưởng thành qua giai đoạn trophozoite rồi đến schizonts, ly giiar thêm merozoites vào trong dòng máu rồi có thể nhiễm vào các tế bào hồng cầu khác. Các triệu chứng xảy ra trong giai đoạn hồng cầu này, thường 1-4 tuần sau khi muỗi đốt.
4 loài Plasmodia thường gây bệnh sốt rét ở người. Tất cả đều tiêu hóa hemoglobin và gây tình trạng tan huyết. P. falciparum là loài duy nhất đến giờ gây nguy hiểm, một phần vì nó có thể làm thay đổi bề mặt hồng cầu và gây tắc nghẽn hệ vi mạch máu. Ngoài ra, P.falciparum có thể có mật độ ký sinh trùng cao trong máu vì chúng có thể nhiễm vào bất kỳ một loại tế bào hồng cầu nào trong quá trình trưởng thành của chúng. Ngược lại, P. vivax và P. ovale chỉ xâm nhập vào các tế bào lưới, vì thế mật độ ký sinh trùng thấp (< 1%). P vivax và P. ovale còn có thể ngủ trong gan (hypnozoites), điều này có thể gây cơn tái phát, thường trong vòng 3 năm phơi nhiễm. Sốt rét P. falciparum không có thể ngủ, vì thế cơn tái phát không xảy ra. Nhiễm sốt rét do P malariae chỉ nhiễm vào trong các tế bào hồng cầu trưởng thành, nên cũng chỉ sinh ra mật độ ký sinh trùng thấp. Loài ký sinh trùng sốt rét thứ 5 vốn dĩ ký sinh trên khỉ, là nguyên nhân hiếm gặp và gây ra sốt rét ác tính ở người.
Đến ½ tỷ ca sốt rét xảy ra trên toàn cầu mỗi năm. Mặc dù bệnh chủ yếu ở các vùng SRLH, khoảng 30.000 du khách từ các quốc gia công nghiệp bị nhiễm mỗi năm. Ít hơn 1.000 ca được báo cáo tại Mỹ hàng năm, điều này thường mắc phải trong suốt thời gian đi du lịch đến các vùng SRLH. Nguy cơ lây truyền khác nhau từ vùng này sang vùng khác, tỷ lệ cao nhất (liệt kê theo thứ tự thấp dần) xảy ra ở Oceania, sub-Saharan Africa, Ấn Độ, Đông Nam Á, Nam Mỹ và Trung Mỹ. hơn 3 triệu người chết vì sốt rét mỗi năm, hầu hết họ là từ vùng cận sa mạc Sahara, châu Phi.
Sốt rét lan truyền chủ yếu qua muỗi cái Anopheles đốt nhưng cũng có thể lây truyền do truyền máu, do dùng chung bơm tiêm, qua đường nhau thai, sốt rét bẩm sinh và do cấy ghép các cơ quan. Vì sự di cư và dân di biến động đến Mỹ từ các vùng sốt rét lưu hành, nên tình trạng mắc sốt rét ngày càng tăng; bệnh cũng có thể lây truyền qua máy bay (“airport malaria”). Không có ổ chứa động vật cho ký sinh trùng sốt rét ở người.
Sốt hồi quy
Sốt khá phổ biến và không cần quan tâm đến loài nào gây bệnh. Triệu chứng hay gặp gồm suy nhược, run lạnh, nhức đầu, đau cơ, đau bụng, ra mồi hôi, nôn và tiêu chảy. Các giai đoạn sốt, thường khởi đầu và không thường xuyên, có thể đều đặn lệ thuộc vào từng loài nhiễm bệnh. Độ nặng thường giảm theo thời gian. Cuối cùng là thiếu máu, giảm tiểu cầu, vàng da, lách to, gan to.
Sốt rét do P. falciparum có thể dẫn đến phù phổi cấp, suy thận, viêm dạ dày ruột, hạ đường huyết, xuất huyết. SRAT thể não biểu hiện rối loạn ý thức hoặc có cơn co giật, thậm chí thử vong. Tử vong thường do không điều trị, liên quan đến mật độ ký sinh trùng. Độ nặng của bệnh thường diễn ra trên trẻ em, phụ nữ mang thai, bệnh nhân không có chức năng lách bình thường hoặc đã cắt bỏ lách, người không có miễn dịch.
Nhiễm trùng P. vivax hoặc P. ovale không sinh ra các biến chứng trong hệ vi mạch do sốt rét P. falciparum và giảm tiểu cầu ít gặp hơn. Nhiễm trùng P. malariae có thể dẫn đến lắng đọng phức hợp miễn dịch và gây hội chứng thận hư. Các triệu chứng có thể nhẹ và thường kéo dài.
Cân nhắc sốt rét trên những người du lịch có biểu hiện sốt tái hồi
Bệnh sốt rét nên được nghi ngờ trên những bệnh nhân có sốt, trước đó đi du lịch đến vùng lưu hành bệnh. Ngay cả một số người không có đi du lịch, sốt rét cũng nên được cân nhắc đặt ra chẩn đoán phân biệt với sốt không rõ nguyên nhân. Chẩn đoán thông qua phát hiện các ký sinh trùng sốt rét trong hồng cầu trên tiêu bản máu nhuộm giêm sa. Các lam máu giọt dày đặc biệt rất nhạy, nhưng giọt mỏng lại hữu ích để phát hiện và xác định các loài và dùng để ước tính mật độ ký sinh trùng. Lam máu đầu tiên dương tính > 90% số ca. Nếu âm tính, cần lấy thêm lam máu mỗi 6-12 giờ trong vòng 48 giờ vì chu kỳ tự nhiên của ký sinh trùng. Nếu cần thiết, phải soi lên đến 200-300 vi trường trước khi kết luận lam máu âm tính.
Các test chẩn đoán nhanh (RDTs) phát hiện kháng nguyên rất hữu ích trong chẩn đoán. Các dụng cụ xét nghiệm này có thể mang đi dễ dàng và cho kết quả nhanh trong vòng 15 phút. Phản ứng PCR mang lại kết quả chính xác với độ nhạy và độ đặc hiệu cao, nhưng hơi đắt tiền; do đó, các kỹ thuật cao này chỉ hạn chế trong các la bô nghiên cứu và nghiên cứu sâu về kháng thuốc.
Quản lý bệnh nhân nghi ngờ sốt rét nên thực hiện và do các nhân viên kinh nghiệm. Các khuyến cáo về điều trị sốt rét theo từng chính sách và hướng dẫn của mỗi quốc gia. Việc lựa chọn thuốc đòi hỏi thầy thuốc lâm sàng phải có kiến thức về phân bố kháng thuốc sốt rét theo vùng và các tác dụng phụ của thuốc. Các bệnh nhân sốt rét không do P. falciparum hiếm khi đòi hỏi phải nhập viện.
 |
Hình 4. Plasmodium vivax: thể nhẫn trong hồng cầu (mũi tên) và các thể tư dưỡng trưởng thành (mũi tên dài) qua nhuộm Giemsa, độ phóng đại × 100). |
BỆNH TRYPANOSOMIASIS CHÂU MỸ (hay bệnh CHAGAS)
Bệnh do đơn bào trypanosoma châu Mỹ (American trypanosomiasis) là một bệnh truyền từ động vật sang người, do đơn bào có tên là Trypanosoma cruzi. Ký sinh trùng lan truyền qua côn trùng hút máu, hay gọi là “kissing bugs”. Các côn trùng này ưa thích các gạch ẩm, tường vách đất sét, nơi đó chúng sống trong cách vách gạch, dưới gỗ và sau các bức tranh. Các côn trùng này mắc phải các vi trùng do ăn phải trên các động vật hoặc người nhiễm và tồn tại thể trypomastigotes trong máu. Tiếp đến các ký sinh trùng này nhân lên trong ruột côn trùng và lây truyền đến vật chủ có cột sống thứ 2 và thải phân sau bữa ăn. Ký sinh trùng đi vào cơ thể thông qua vết ở da, kết mạc hoặc niêm mạc. Sau khi vào cơ thể, ký sinh trùng sẽ lan tỏa khắp cơ thể khắp dòng máu, xâm nhập vào nhiều loại tế bào, đặc biệt là cơ và thần kinh.
Bệnh do đơn bào trypanosoma châu Mỹ xảy ra ở Trung và Nam Mỹ, Mexico và vùng phía nam của nước Mỹ. Khoảng 16-18 triệu người nhiễm ký sinh trùng này và gần 50.000 người chết mỗi năm, thường do biến chứng ở tim. Một khi hạn hữu ở nông thôn, bệnh giwof còn phổ biến ở các thành phố. Phần lớn số ca báo cáo từ Brazil. Chỉ một số ca được báo cáo tại Mỹ, nhưng 50.000 -100.000 dân di biến động bị nhiễm. Sự lây truyền ký sinh trùng có thể cũng xảy ra qua truyền máu, cấy ghép cơ quan và nhau thai. Sự gia tăng những trường hợp liên quan đến truyền máu tại Mỹ vì một trào lưu nhân công lao động từ Mexico và Trung Mỹ.
Pha cấp tính có thể thay đổi từ không triệu chứng đến liên quan ảnh hưởng đến nhiều cơ quan.
Hầu hết những người nhiễm không triệu chứng. Chỉ có 1% trở thành bệnh có triệu chứng, nhưng đến 1/3 số người nhiễm phát triển đến các thể bệnh mạn tính hàng chục năm sau đó. Bệnh Chagas cấp tính thường gặp trên trẻ em, biểu hiện sốt, suy nhược, chán ăn và thường kèm theo nôn mửa, tiêu chảy và phát ban. Tim, gan và hạch lympho lớn. có các nốt đỏ, nhú lên (chagoma) xuất hiện ở vùng bị đốt. Nếuđốt xảy ra qua kết mạc, sẽ có dấu đau phù mắt và mô xung quanh (dấu Romaña). Bệnh lý hạch lympho toàn thân và gan lách to có thể nhìn thấy.
Viêm cơ tim và viêm não màng não xảy ra trong một số trường hợp cấp của bệnh Chagas. Viêm cơ tim có thể lan rộng đến ngoại tâm mạc, gây nên tình trạng tràn dịch màng ngoài tim và màng trong tim, hình thành các cục huyết khối. tất cả buồn tim có thể phì đai và hệ thống dẫn truyền bị gián đoạn. Tổn thương não do viêm não màng não thường xảy ra trên trẻ em nhỏ và có thể dẫn đến tử vong.
Pha cấp tính này kéo dài 4-8 tuần và biểu hiện đặc trưng bởi ký sinh trùng nằm trong sâu, xâm nhập vào mô và gây phản ứng viêm. Theo sau pha cấp là một giai đoạn không triệu chứng tiềm tàng hoặc pha không xác định, có thể kéo dài từ 10-40 năm. Ít hơn một nửa trong số này có biểu hiện lâm sàng tiềm tàng và đi vào pha mạn tính của bệnh.  |
Hình 5. Thể hình chữ C của trypomastigotes của Trypanosoma cruzi (nhuộm Wright). |
Giai đoạn mạn tính nghiêm trọng có thể xảy ra hàng chục năm sau đó
Trong pha mạn tính, điều này xảy ra từ vài năm đến thập kỷ kể từ khi nhiễm trùng ban đầu, bệnh đặc trưng bởi phình lớn các cơ quan tim, thực quản, đại tràng. Liên quan đến tim là biểu hiện hình ảnh suy tim sung huyết, rối loạn nhịp và ngừng tim. Cục huyết khối trong tim có thể gây cục nghẽn, gây tình trạng nhồi máu tim và phổi. Thực quản trương phình liên quan đến khó ăn, đau ngực, sụt cân, đôi khi viêm phổi do rò thủng. Đại tràng lớn có thể dẫn đến táo bón, co thắt bụng, đau, tắc ruột. Đôi khi, cũng nhìn thấy hình ảnh dãn ruột non, niệu quản và phế quản. Các xét nghiệm cận lâm sàng cho thấy mật độ ký sinh trùng thấp, viêm các mô, suy gimar miễn dịch của hệ thống vi mạch.
Chẩn đoán: Bằng chứng có đơn bào trong giai đoạn cấp tính
Trong giai đoạn cấp tính, bệnh Chagas được chẩn đoán nhờ vào nhỏ giọt máu trên lam không nhuộm. Hình ảnh đơn bào di động nhanh có thể nhìn thấy ở độ phóng đại gấp x 400 lần. Ít nhất 100 vi trường là cần phải soi. Lam máu nhuộm ít nhạy hơn, nhưng có thể cho phép nhìn các nhân, kinetoplast và các roi. Kỹ thuật tập trung máu có thể dùng khi xét nghiệm ban đầu không nhìn thấy.
Các xét nghiệm huyết thanh rất hữu ích trong chẩn đoán bệnh Chagas mạn tính. Đơn bào có thể xác định nhờ vào phản ứng PCR, nhưng độ nhạy của test này thay đổi khác nhau.
Điều trị làm giảm các triệu chứng
Hai loại thuốc được sử dụng để điều trị bệnh trypanosomiasis châu Mỹ. Nifurtimox (Lampit) giảm thời gian xuất hiện triệu chứng và tính trầm trọng của triệu chứng cũng như giảm tỷ lệ tử vong trong bệnh Chagas bẩm sinh và cấp tính; tuy nhiên, ít hơn 70% số bệnh nhân được chữa khỏi về mặt ký sinh trùng và tác dụng phụ không đáng kể. Benznidazole (Rochagan, Radanil) có hiệu lực tương tự với Nifurtimox và nó được xem là một thuốc lựa chọn ở châu Mỹ Latin. Các thuốc này không có sẵn trên thị trường Mỹ. Liệu pháp có thể giúp cho trường hợp chưa xác định nhưng hiếm khi lựa chọn trong bệnh lý Chagas mạn tính. Điều trị bệnh Chagas bằng các triazoles hiện vẫn chưa đánh giá rõ ràng.
Tài liệu tham khảo
1.KroftSH. Infectious diseases manifested in the peripheral blood. Clin Lab Med2002; 22:253–277.
2.MeldrumSC, BirkheadGS, WhiteDJ, BenachJL, MorseDL. Human babesiosis in New York State: an epidemiological description of 136 cases. Clin Infect Dis1992; 15:1019–1023.
3.PruthiRK, MarshallWF, WiltsieJC, PersingDH. Human babesiosis. Mayo Clin Proc1995; 70:853–862.
4.EskowES, KrausePJ, SpielmanA, FreemanK, AslanzadehJ. Southern extension of the range of human babesiosis in the eastern United States. J Clin Microbiol1999; 37:2051–2052.
5.QuickRE, HerwaldtBL, ThomfordJW. Babesiosis in Washington State: a new species of Babesia?Ann Intern Med1993; 119:284–290.
6.PersingDH, HerwaldtBL, GlaserC et al.Infection with a babesia-like organism in northern California. N Engl J Med1995; 332:298–303.
7.GorenflotA, MoubriK, PrecigoutE, CarcyB, SchettersTP. Human babesiosis. Ann Trop Med Parasitol1998; 92:489–501.
8.VillarBF, WhiteDJ, BenachJL. Human babesiosis. Prog Clin Parasitol1991; 2:129–143.
9.SunT, TenenbaumMJ, GreenspanJ et al. Morphologic and clinical observations in human infection with Babesia microti. J Infect Dis1983; 148:239–248.
10.BenachJL, HabichtGS. Clinical characteristics of human babesiosis. J Infect Dis1981; 144:481.
11.BoustaniMR, GelfandJA. Babesiosis. Clin Infect Dis1996; 22:611–615.
12.Meer-ScherrerL, AdelsonM, MordechaiE, LottazB, TiltonR. Babesia microti infection in Europe.Curr Microbiol2004; 48:435–437.
13.KrausePJ. Babesiosis diagnosis and treatment. Vector Borne Zoonotic Dis2003: 3:45–51.
14.PersingDH, MathiesenD, MarshallWF et al.Detection of Babesia microti by polymerase chain reaction. J Clin Microbiol1992; 30:2097–2103.
15.ChisholmES, SulzerAJ, RuebushTK, 2nd. Indirect immunofluorescence test for human Babesia microti infection: antigen specificity. Am J Trop Med Hyg1986; 35:921–925.
16.BerryA, MorassinB, KamarN, MagnavalJF. Clinical picture: human babesiosis. Lancet2001; 357:341.
17.MaedaK, MarkowitzN, HawleyR, RisticM, CoxD, McDadeJE. Human infection with Ehrlichia canis, a leukocytic rickettsia. N Engl J Med1987; 316:853–856.
18.ChenSM, DumlerJS, BakkenJS, WalkerDH. Identification of a granulocytotrophic Ehrlichia species as the etiologic agent of human disease. J Clin Microbiol1994; 32:589–595.
19.LockhartJM, DavidsonWR, StallknechtDE, DawsonJE, HowerthEW. Isolation of Ehrlichia chaffeensis from wild white-tailed deer (Odocoileus virginianus) confirms their role as natural reservoir hosts. J Clin Microbiol1997; 35:1681–1686.
20.StoneJH, DierbergK, AramG, DumlerJS. Human monocytic erhlichiosis. JAMA2004; 292:2263–2270.
21.BakkenJS, DumlerJS. Human granulocytic ehrlichiosis. Clin Infect Dis2000; 31:554–560.
22.DumlerJS, BakkenJS. Ehrlichial diseases of humans: emerging tick-borne infections. Clin Infect Dis1995; 20:1102–1110.
23.EverettED, EvansKA, HenryRB, McDonaldG. Human ehrlichiosis in adults after tick exposure. Diagnosis using polymerase chain reaction. Ann Intern Med1994; 120:730–735.
24.FishbeinDB, DawsonJE, RobinsonLE. Human ehrlichiosis in the United States, 1985 to 1990. Ann Intern Med1994; 120:736–743.
25.BakkenJS, KruethJ, Wilson-NordskogC, TildenRL, AsanovichK, DumlerJS. Clinical and laboratory characteristics of human granulocytic ehrlichiosis. JAMA1996; 275:199–205.
26.RatnasamyN, EverettED, RolandWE, McDonaldG, CaldwellCW. Central nervous system manifestations of human ehrlichiosis. Clin Infect Dis1996; 23:314–319.
27.VanekNN, KaziS, CeperoNM, TangS, RexJH. Human ehrlichiosis causing left ventricular dilation and dysfunction. Clin Infect Dis1996; 22:386–387.
28.BakkenJS, Aguero-RosenfeldME, TildenRL et al.Serial measurements of hematologic counts during the active phase of human granulocytic ehrlichiosis. Clin Infect Dis2001; 32:862–870.
29.HamiltonKS, StandaertSM, KinneyMC. Characteristic peripheral blood findings in human ehrlichiosis. Mod Path2004; 17:512–517.
30.DawsonJE, FishbeinDB, EngTR, RedusMA, GreenNR. Diagnosis of human ehrlichiosis with the indirect fluorescent antibody test: kinetics and specificity. J Infect Dis1990; 162:91–95.
31.WallsJJ, CaturegliP, BakkenJS, AsanovichKM, DumlerJS. Improved sensitivity of PCR for diagnosis of human granulocytic ehrlichiosis using epank1 genes of Ehrlichia phagocytophila-group ehrlichiae. J Clin Microbiol2000; 38:354–356.
32.BarbourAG, GoodmanJL, DennisDT, SonenshineDE. Relapsing fever. In: Goodman JL, Dennis DT, Sonenshine DE, editors. Tick-Borne Diseases of Humans. Washington, DC: ASM Press; 2005:268.
33.BarbourAG, HayesSF. Biology of Borrelia species. Microbiol Rev1986; 50:381–400.
34.HoogstraalH. Ticks and spirochetes. Acta Trop1979; 36:133–136.
35.SonenshineD. Biology of Ticks. New York, NY: Oxford University Press; 1991.
36.FelsenfeldO. Borrelia; Strains, Vectors, Human, and Animal Borreliosis. St Louis, MO: Warren H Greene, Inc; 1971.
37.BrycesonAD, ParryEH, PerinePL, WarrellDA, VukotichD, LeitheadCS. Louse-borne relapsing fever. Q J Med1970; 39:129–170.
38.JudgeDM, SamuelI, PerinePL, VukoticD, AbabaA. Louse-borne relapsing fever in man. Arch Pathol1974; 97:136–170.
39.SouthernP, SanfordJ. Relapsing fever. A clinical and microbiological review. Medicine1969; 48:129–149.
40.BarbourAG. Antigenic variation of a relapsing fever Borrelia species. Annu Rev Microbiol1990; 44:155–171.
41.StoennerHG, DoddT, LarsenC. Antigenic variation of Borrelia hermsii. J Exp Med1982; 156:1297–1311.
42.BarbourAG. Immunobiology of relapsing fever. Contrib Microbiol Immunol1987; 8:125–137.
43.ScottR. Neurological complications of relapsing fever. Lancet1944; 247:436–438.
44.CadavidD, BarbourAG. Neuroborreliosis during relapsing fever: review of the clinical manifestations, pathology, and treatment of infections in humans and experimental animals. Clin Infect Dis1998; 26:151–164.
45.WengrowerD, KnoblerH, GillisS, Chajek-ShaulT. Myocarditis in tick-borne relapsing fever. J Infect Dis1984; 149:1033.
46.PerinePL, ParryEH, VukotichD, WarrellDA, BrycesonAD. Bleeding in louse-borne relapsing fever. I. Clinical studies in 37 patients. Trans R Soc Trop Med Hyg1971; 65:776–781.
47.RheeKY, JohnsonWD, MandellGL, BennettJE, DolinR. Borrelia species (relapsing fever). In: Mandell GL, Bennett JE, Dolin R, editors. Mandell, Douglas, and Bennett’s Principles and Practice of Infectious Diseases. 6th ed. Philadelphia, PA: Elsevier Churchill Livingstone; 2005:2795–2798.
48.GreenwoodBM, BojangK, WhittyCJ, TargettGA.Malaria. Lancet2005; 365:1487–1498
49.NewboldC, CraigA, KyesS, RoweA,Fernandez-ReyesD, FaganT.Cytoadherence, pathogenesis and the infected red cell surface in Plasmodium falciparum. Int J Parasitol1999; 29:927–937.
50.OhSS, ChishtiAH, PalekJ, LiuSC. Erythrocyte membrane alterations in Plasmodium falciparum malaria sequestration. Curr Opin Hematol1997; 4:148–154.
51.SinghB, Kim SungL, MatusopA, et al. . A large focus of naturally acquired Plasmodium knowlesi infections in human beings. Lancet2004; 363:1017–1024.
52.FairhurstRM, WellemsTEMandellGL, BennettJE, DolinR. Plasmodium species (malaria). In: Mandell GL, Bennett JE, Dolin R, editors. Mandell, Douglas, and Bennett’s Principles and Practice of Infectious Diseases. 6th ed. Philadelphia, PA: Elsevier Churchill Livingstone; 2005:3121,3122.
53.FillerS, CauserLM, NewmanRD, et al.Centers for Disease Control and Prevention (CDC). . Malaria surveillance—United States, 2001. MMWR Surveill Summ2003; 52:1–14.
54.OlliaroP, CattaniJ, WirthD. Malaria, the submerged disease. JAMA1996; 275:230–233.
55.KainKC, KeystoneJS. Malaria in travelers. Epidemiology, disease, and prevention. Infect Dis Clin North Am1998; 12:267–284. World Health Organization, Division of Control of Tropical Diseases. Severe and complicated malaria. Trans R Soc Trop Med Hyg1990; 84(suppl 2):1–65
56.FieldJW. Blood examination and prognosis in acute falciparum malaria. Trans R Soc Trop Med Hyg1949; 43:33–48.
57.LemaOE, CarterJY, NagelkerkeN, et al.Comparison of five methods of malaria detection in the outpatient setting. Am J Trop Med Hyg1999; 60:177–182.
58.WhiteNJ. The treatment of malaria. N Engl J Med1996; 335:800–806.
59.MoodyA. Rapid diagnostic tests for malaria parasites. Clin Microbiol Rev2002; 15:66–78.
60.MaklerMT, PalmerCJ, AgerAL. A review of practical techniques for the diagnosis of malaria. Ann Trop Med Parasitol1998; 92:419–433.
61.KirchhoffLV, MandellGL, BennettJE, DolinR. Trypanosoma species (American trypanosomiasis, Chagas’ disease): Biology of trypanosomes. In: Mandell GL, Bennett JE, Dolin R, editors. Mandell, Douglas, and Bennett’s Principles and Practice of Infectious Diseases. 6th ed. Philadelphia, PA: Elsevier Churchill Livingstone; 2005:3157–3158.
62.BarrettMP, BurchmoreRJ, StichA, et al.. The trypanosomiases. Lancet2003; 362:1469–1480.
63.Control of Chagas disease. Report of a WHO Expert Committee. World Health Organ Tech Rep Ser1991; 811:1–95.
64.KirchhoffLV, GuerrantR, WalkerDH, WellerPF. American trypanosomiasis (Chagas’ disease). In: Guerrant R, Walker DH, Weller PF, editors. Tropical Infectious Diseases: Principles, Pathogens and Practice; vol. 1. Philadelphia, PA: Churchill Livingstone; 1999:785.
65.KirchhoffLV. American trypanosomiasis (Chagas’ disease). Gastroenterol Clin North Am1996; 25:517–533.
66.WanderleyDM, CorrêaFM. Epidemiology of Chagas’ heart disease. Sao Paul Med J1995; 113:742–749.
67.SchmuñisGA.Trypanosoma cruzi, the etiologic agent of Chagas’ disease: status in the blood supply in endemic and nonendemic countries. Transfusion1991; 31:547–557
68.KöberleF. Chagas’ disease and Chagas’ syndromes: the pathology of American trypanosomiasis. Adv Parasitol1968; 6:63–116.
69.DiasE, LaranjaFS, MirandaA, NobregaG. Chagas’ disease; a clinical, epidemiologic, and pathologic study. Circulation1956; 14:1035–1060.
70.PrataA, AndradeZ, GuimaraesAC, ShaperAG, HuttMS, FejfarZ.Chagas’ heart disease. In: Shaper AG, Hutt MS, Fejfar Z, editors. Cardiovascular disease in the tropics. London, England: British Medical Association; 1974:264.
71.DiasJC. The indeterminate form of human chronic Chagas’ disease. A clinical epidemiological study. Rev Soc Bras Med Trop1989; 22:147–156.
72.LopesER, TafuriWL.Involvement of the autonomic nervous system in Chagas’ heart disease. Rev Soc Bras Med Trop1983; 16:206.
73.MeneghelliUG. Chagas’ disease: a model of denervation in the study of digestive tract motility. Braz J Med Biol Res1985; 18:255–264.
74.PirardM, IihoshiN, BoelaertM, BasantaP, LopezF, Van der StuyftP. The validity of serologic tests for Trypanosoma cruzi and the effectiveness of transfusional screening strategies in a hyperendemic region. Transfusion2005; 45:554–561.
75.KirchhoffLV, MandellGL, BennettJE, DolinR. Trypanosoma species (American trypanosomiasis, Chagas’ disease): Biology of trypanosomes. In: Mandell GL, Bennett JE, Dolin R, editors. Mandell, Douglas, and Bennett’s Principles and Practice of Infectious Diseases. 6th ed. Philadelphia, PA: Elsevier Churchill Livingstone; 2005:3162–3163.